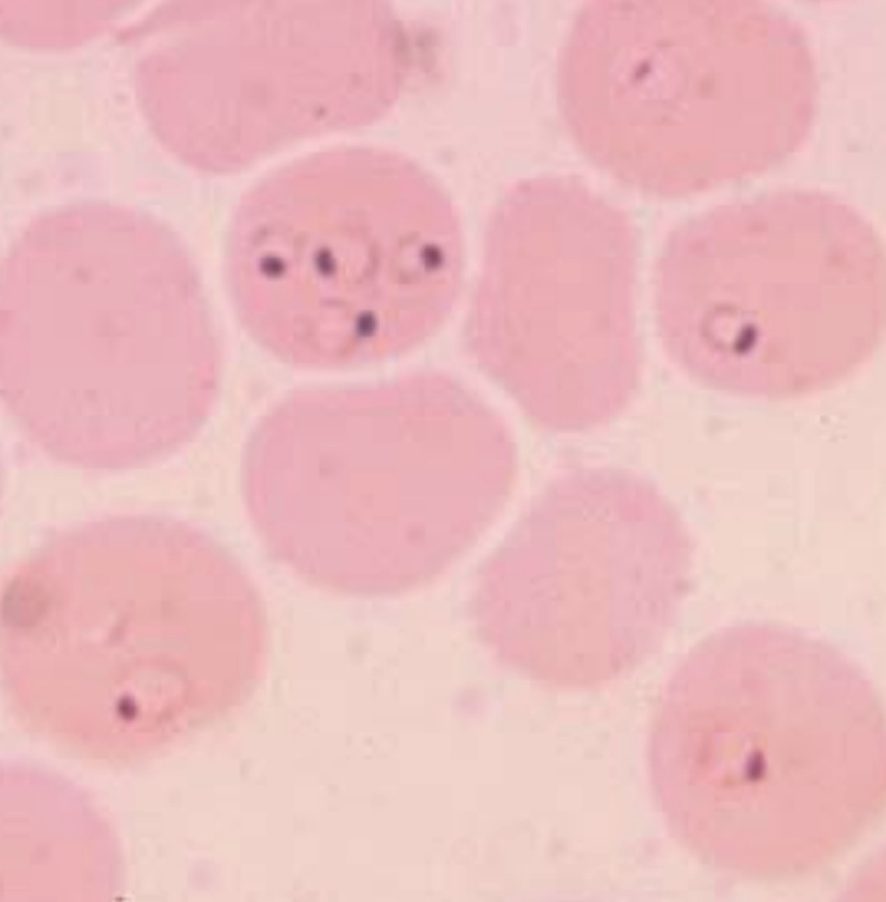
knowt flashcard image
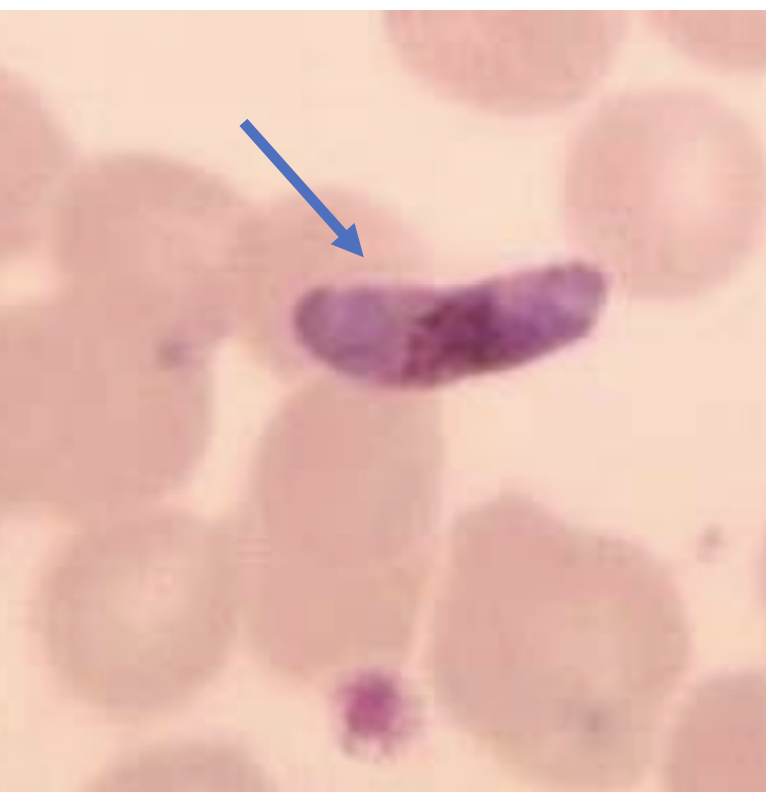
knowt flashcard image
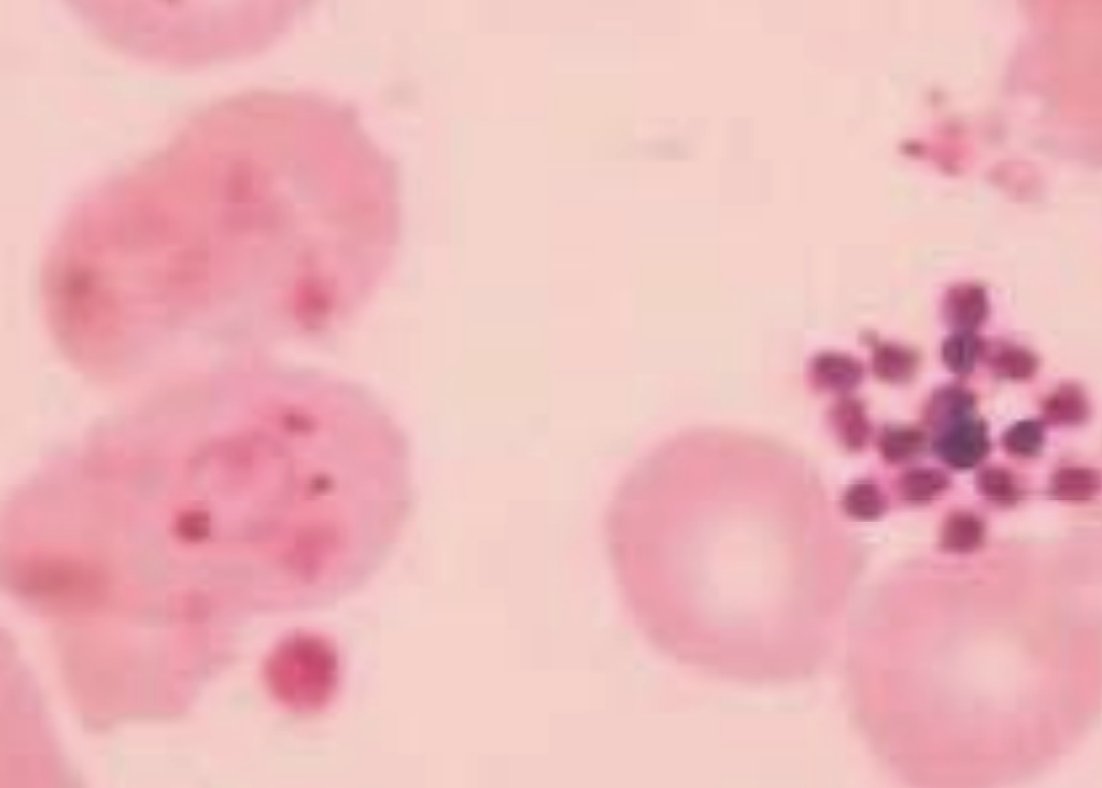
knowt flashcard image
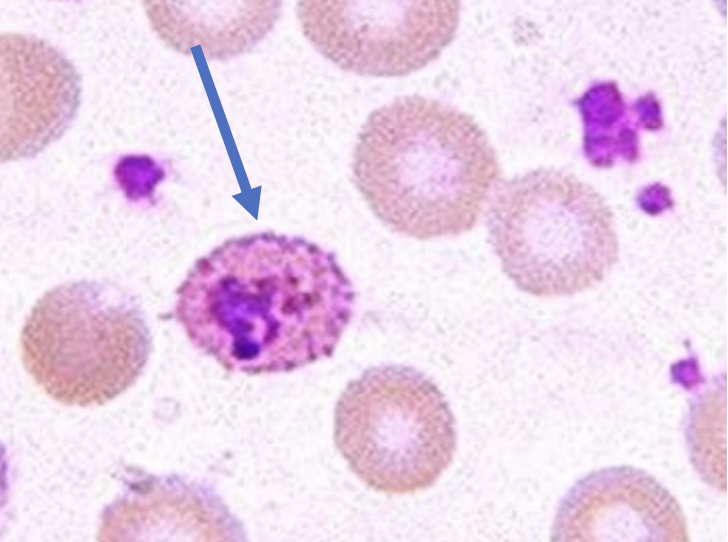
knowt flashcard image
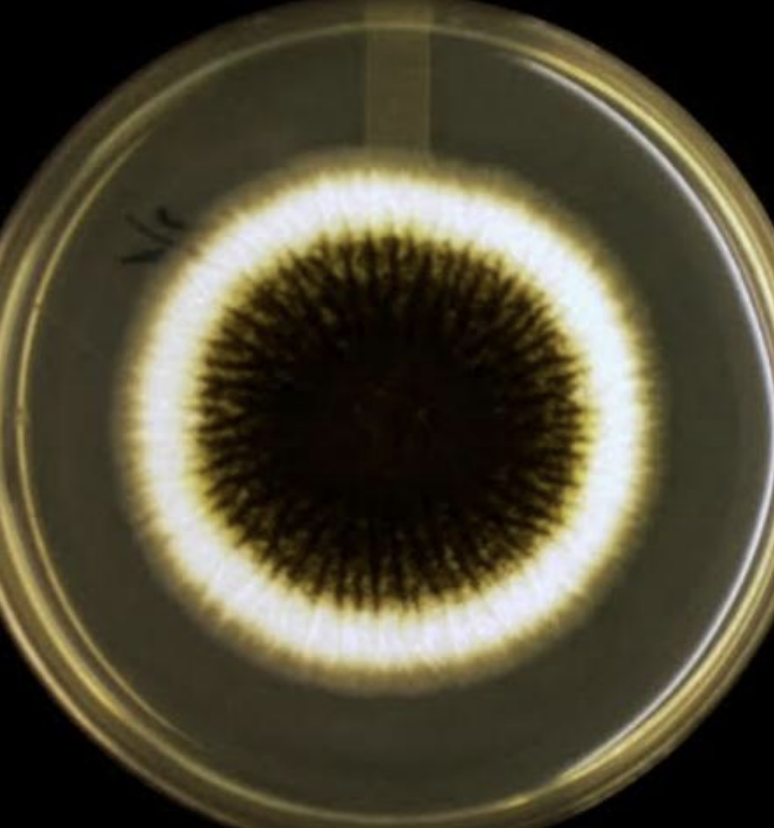
<p>what microbe</p><p>what agar?</p>
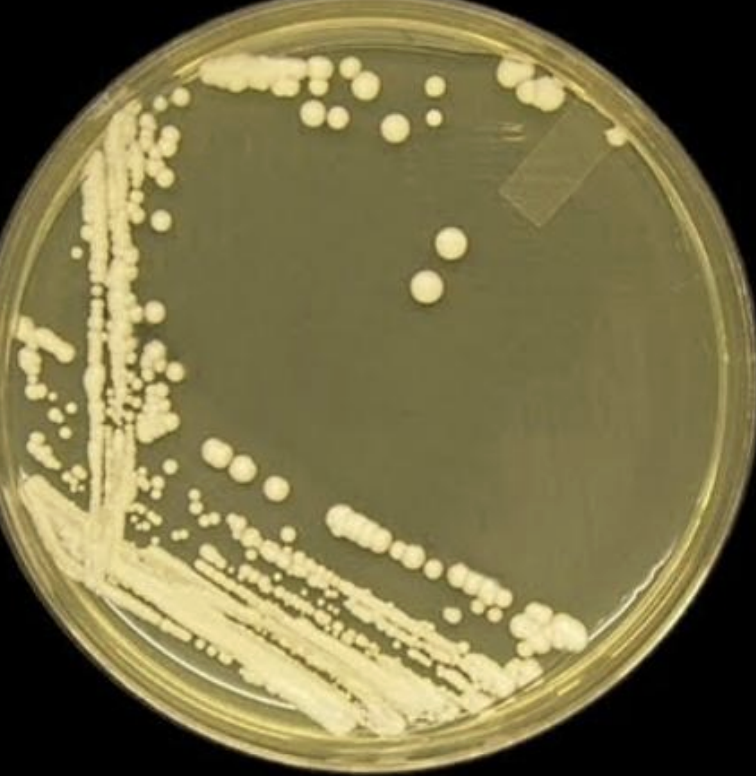
<p>what microbe</p><p>what agar?</p><p>describe?</p>

parasitology / mycology
1/22
There's no tags or description
Looks like no tags are added yet.
Name | Mastery | Learn | Test | Matching | Spaced |
|---|
No study sessions yet.
23 Terms
Intestinal Protozoa
entameoba histolytica trophozoite

Intestinal Protozoa
entameoba histolytica cyct and 4 nuclei inside it

Cryptosporidium parvum oocyst - ZN stain
what microbe
what stain

Plasmodium falciparum – ring form

Plasmodium falciparum – ring form
Plasmodium falciparum-gametocyte
Plasmodium vivax- schizont
Plasmodium vivax- trophozoite
Trypanosoma brucei gambiense

Leishmania donovani
Macrophages filled with Leishmania amastigotes

Toxoplasma gondii

• Anopheles mosquito:
• Definitive host for Plasmodium spp. causing malaria.
• Sand fly (Phlebotomus):
• insect vector for Leishmania spp.
• Tsetse fly (Glossina):
• insect vector for Trypanosomes
Anopheles mosquito

Sandfly

Tsetse fly

Microsporum canis on Sabouraud Dextrose Agar
what microbe
what agar?

Aspergillus niger on Sabouraud Dextrose Agar
what microbe
what agar?
Colonies of C. albicans appear on Sabouraud dextrose agar (SDA) as cream to white, flat or domed with a dry or waxy surface
what microbe
what agar?
describe?
Candida albicans- budding cells

Germ tubes are short outgrowths, non-septate, slender, tube-like structures. • When cells of Candida are incubated in serum at 37°C for 2-4 hours, Candida albicans and Candida dubliniensis produce germ tubes. • Other non-albicans candida species donnot produce it.
what microbe(s)?
describe shape?
time /T incubation?

Cryptococcus neoformans capsule is shown using negative stain ( indian ink stain
microbe?
stain?